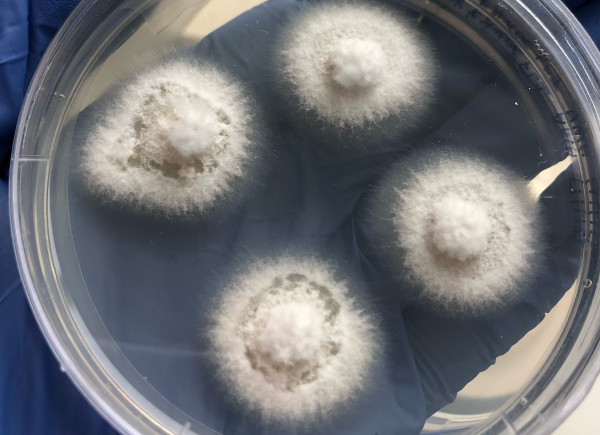

Ngā harore pohewanga o Aotearoa - Te mārama ki ngā momo puruheka

Dr Essie Van Zuylen (photo supplied)
He rongoā ka tupu noa iho ko te Psilocybin, ka whakaputaina e te hekaheka, ā, ka kaingia ana ko te pohewatanga te hua. Kei te hiahiatia te psilocybin me ētahi atu pūhui matū hei rongoā pai mō ētahi momo mate hinengaro pēnei i te kōtonga, i te āwangawanga, i te kōhuki taumuri, i te raukoti pūroi me te warawara. Ahakoa kātahi anō ka tirohia te whakamahinga o te psilocybin me ana hekaheka, kua roa ngā hekaheka pohewa e whakamahia ana e ngā iwi taketake puta noa i te ao. Hei tā te mātauranga Māori i whakamahia e ō tātou tūpuna te hekaheka hei kai, hei rongoā anō hoki, engari, he nui tonu ngā āhuatanga me ako e pā ana ki ā tātou momo taonga pohewa. Ka whakahuatia e te rīpoata uiui a te Kāwanatanga o Aotearoa mō te Hauora Hinengaro me te Warawara he nui noa atu te pāpātanga o te mate hinengaro, whakamomori, me te warawara kua pāngia e te Māori, ka mutu, kāore i pai ngā putanga mō te whai wāhi ki te ratonga hauora. E ngana ana tēnei rangahau ki te waihanga i tētahi pātaka mātauranga mō ngā momo hekaheka taketake, te Psilocybe weraroa, me ngā whanaunga, e tūhura ana i te huaira, i te mātai koiora, i te mātu matū anō hoki nā runga i te tirohanga o te Māori kia hua mai ai ana hua hei pānuitanga rongoā mate hinengaro mā te whānau.
Fungal mycelia growing on an agar plate (photo supplied).
